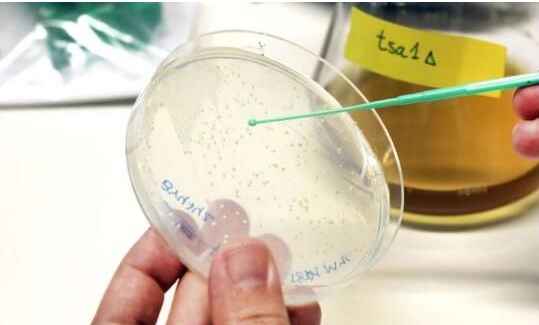

eLife解读!氧化剂或能帮助减缓细胞的衰老过程!
2020年11月18日 讯 /生物谷BIOON/ --近日,一项刊登在国际杂志eLife上题为“Peroxiredoxin promotes longevity and H2O2-resistance in yeast through redox-modulation of protein kinase A”的研究报告中,来自查尔姆斯理工大学等机构的科学家们通过研究发现,氧化剂或能有效减缓机体细胞的衰老过程。在高浓度下,被称为氧化剂的活性氧对所有生物体的细胞都是有害的,然而这项研究中,研究人员却发现,低水平的氧化剂—过氧化氢或能刺激一种特殊酶类来帮助减缓酵母细胞的衰老。
图片来源:Martina Butorac/Chalmers University of Technology
诸如维生素C和维生素E等抗氧化剂的益处之一就是其能有效中和机体中的活性氧自由基(即所谓的氧化剂),否则其就会与机体中其它重要分子发生反应并破坏其生物学功能,比如大量的氧化剂会对DNA、细胞膜和蛋白质产生严重的损害,因此机体的细胞已经发展出了强大的防御性机制来摆脱这些在机体正常新陈代谢过程中所产生的氧化剂。此前人们认为,氧化剂只是有害的,但最近科学家们才开始理解其所产生的积极性功能,研究人员发现,众所周知的抗氧化剂过氧化氢实际上能够减缓酵母细胞的衰老进程,其是一种用于头发和牙齿美白等用途的化学物质,也是机体新陈代谢所产生的氧化剂之一,在较高浓度下是有害的。
文章中,研究人员对名为Tsa1的酶类进行了深入研究,Tas1是一组被称为抗氧化蛋白(peroxiredoxins)的抗氧化剂的一部分;研究者Mikael Molin说道,此前对这些酶类的研究结果表明,该酶能参与到酵母细胞抵御有害氧化剂的过程中,但当抗氧化蛋白被用于卡路里限制时,其还能帮助延长细胞的寿命,但研究人员并不清楚其背后的分子机制。如今研究人员知道,减少卡路里的摄入能够明显延长多种有机体的寿命(从酵母到猴子等),当通过食物获取比正常情况下少的热量时,刺激抗氧化蛋白的活性或能减缓诸如酵母、果蝇和线虫等有机体细胞的衰老。
如今研究人员发现了Tas1的新功能,此前研究者认为,这种酶类能够简单地中和活性氧自由基,但如今他们发现,Tas1实际上需要一定量的过氧化氢来诱发,从而参与到减缓酵母细胞的衰老过程中去。让研究人员不可思议的是,Tsa1并不会影响老化酵母细胞中过氧化氢的水平,相反,当细胞获得较少热量时,Tsa1就能利用少量的过氧化氢来降低中央信号通路的活性,这种效应最终会导致细胞分裂和与细胞基本元件形成相关的过程减慢,细胞抵御压力的防御反应也会被激发,从而就会促进细胞衰老地更慢一些。研究者Mikael Molin表示,受卡路里摄入所影响的信号通路或能通过感知多种细胞过程并控制细胞过程在机体衰老过程中扮演关键角色,通过对这一过程进行研究,研究人员希望能够阐明常见疾病发生背后的分子机制,比如癌症、阿尔兹海默病和糖尿病等。

图片来源:Mikael Molin/Chalmers University of Technology
实际上,如今研究人员在理解氧化剂到底是如何真正减缓机体衰老过程的背后分子机制又向前迈进了一步,这或许有望帮助他们开展一些新的研究,比如寻找刺激抗氧化蛋白的药物或检测是否利用其它增强机体氧化剂积极性效应的药物就能减缓年龄相关的疾病。这项研究中,研究人员揭示了抗氧化蛋白酶类Tsa1直接控制中央信号通路的分子机制,其能够通过氧化名为蛋白激酶A的另外一种酶类中的氨基酸来帮助减缓机体衰老,蛋白激酶A对于机体的代谢调节非常重要,这种氧化作用能通过使与其它分子结合的酶类的一部分变得不稳定来降低蛋白激酶A的活性,因此,通过蛋白激酶A所介导的营养信号就会被降低,从而下调细胞的分裂并刺激机体抵御压力的防御性反应。
其它研究结果还表明,低水平的活性氧自由基还与多种积极性的健康效应直接相关,这些氧化剂是在线粒体中形成的,在包括从酵母到小鼠等多种生物体中,研究人员都能够观察到线粒体低毒兴奋效应(mitohormesis),在小鼠机体中,肿瘤的生长就能被线粒体的低毒兴奋效应所减缓,而在线虫中,研究人员则能将抗氧化蛋白与线粒体低毒兴奋效应与2型糖尿病药物二甲双胍减缓细胞衰老的能力关联起来。
二甲双胍对于科学家们寻找能降低受COVID-19严重影响的老年人患病风险的药物具有重要意义,目前来自中国和美国的科学家们已经取得了一些非常有希望的研究结果,其中一种理论就认为,二甲双胍或能抵消受老化所影响的机体免疫系统的恶化表现。(生物谷Bioon.com)

